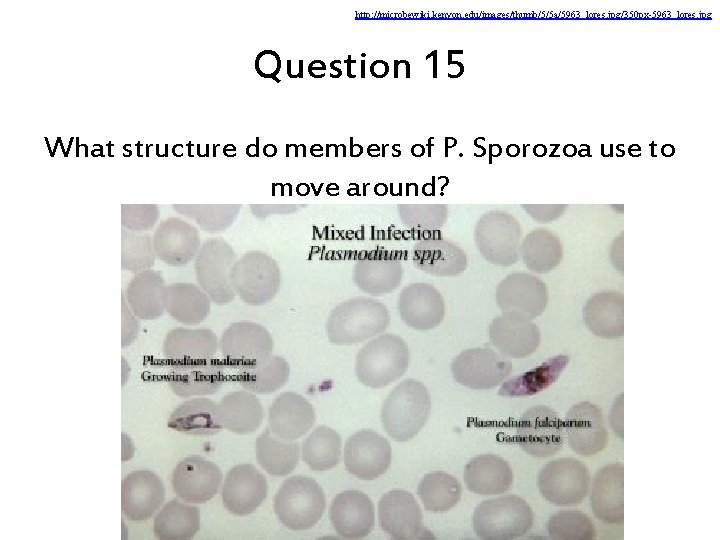
http: //microbewiki. kenyon. edu/images/thumb/5/5 a/5963_lores. jpg/350 px-5963_lores. jpg Question 15 What structure do members

Discussion Game Teams 7 13 23 2 9

- Slides: 39
Discussion Game Teams 7, 13, 23 2, 9, 30 8, 17, 21 5, 14, 29 6, 11, 25 4, 15, 28 3, 10, 24 12, 18, 27 1, 16, 22 19, 20, 26
Question 1 What does the term “protozoa” mean? http: //www. biologyreference. com/images/biol_04_img 0381. jpg
Question 2 Why are protozoans considered animal-like? http: //huntertrek. com/wp/2008/02/25/our-little-amoeba/
Kingdom Protista Plant-like Fungus-like Animal-like protozoa Phylum Zoomastigina Phylum Ciliophora Phylum Sarcodina http: //25. media. tumblr. com/tumblr_m 9425 n 9 q. AW 1 qievavo 1_1280. jpg Phylum Sporozoa
Question 3 What is the basis for classifying protozoa into the four different phyla? Trichomonas vaginalis Euplotes and Stolonychia Amoeba proteus Zoomastigina Ciliophora Sarcodina Plasmodium falciparum gametocytes Sporozoa http: //www. innermostsecrets. com/Images/FIGvaginalis 02. jpg , http: //www. microscopy-uk. org. uk/mag/indexmag. html? http: //www. microscopyuk. org. uk/mag/wimsmall/cilidr. html, http: //library. thinkquest. org/10952/students/2 -truc/AMOEBA. GIF, http: //en. wikipedia. org/wiki/File: Plasmodium_falciparum_01. png
Question 4 What structure do members of P. Zoomastigina use to move around? http: //www. youtube. com/watch? v=R 5 FXWvl. J 2 mk
Phylum Zoomastigina • • Gr. mastix, “whip” Symbiotic relationship: Trichonympha in termites movement: flagella feeding: absorbs food through CM habitat – lakes, streams – solitary, colonial – free-living, symbiotic (some parasitic) • reproduction: binary fission, meiosis • importance: symbionts, food sources in aquatic systems, decomposers
Question 5 Termites provide the Trichonympha with shelter and nutrients, in return, these protists digest an important carbohydrate in the termite diet. What is this carbohydrate called? http: //www. sfu. ca/~fankbone/v/termitesym. jpg
Question 6 Which zooflagellate causes African sleeping sickness?
Trypanosomiasis a. k. a. African sleeping sickness Pathogen: Trypanosoma brucei gambiense (West African sleeping sickness) Trypanosoma brucei rhodesiense (East African sleeping sickness) Vector: Glossina, tsetse fly
Trichomonas infection Pathogen Trichomonas vaginalis Transmission sexual activity; more common in women w/ multiple sexual partners
http: //www. youtube. com/watch? v=3 og. FBAo. Zjo 8 Question 7 What structure do members of P. Ciliophora use to move around?
http: //www. youtube. com/watch? v=pah. Ut 0 RCKYc Question 8 What is the purpose of the pointed structure?
Question 9 Which organelle contains chemicals that aid ciliates in digesting their food intracellularly?
• habitat – fresh/saltwater Phylum Ciliophora • w/ contractile vacuole – mostly free-living • feeding: – cilia pushes food gullet food vacuoles food vacuole + lysosome digestion and circulation waste mat’ls anal pore http: //www. quia. com/files/quia/users/lmcgee/protistpi ctures/AP_Chpt_28_Protists/Paramecium-diagramlabeled. gif
http: //www. youtube. com/watch? v=Gz. A 5 w 7 qxwg 0 Question 10 What do you call the reproductive process shown here?
Question 11 What do you call the reproductive process shown here?
Phylum Ciliophora • reproduction: – binary fission – conjugation • sexual reproduction process • process involves micronuclei: – 2 paramecia attach – 2 n micronucleus: meiosis mitosis – paramecia exchange micronuclei http: //members. multimania. co. uk/wbiolab/images/Paramecium%20 Sexual%20 Reproduction%20 -%20 Conjugation. gif
Question 12 What do you call protective cells of the paramecium shown here?
Phylum Ciliophora • defense: trichocysts – small, bottle-shaped structures found just below the surface http: //www. microscopy-uk. org. uk/mag/imagsmall/parameciumtrichocysts 2 b. jpg , http: //www. youtube. com/watch? v=HMWQL 4 B 4 YCA
http: //www. youtube. com/watch? v=3 og. FBAo. Zjo 8 Question 13 What structure do members of P. Sarcodina use to move around?
Phylum Sarcodina movement: amoeboid pseudopodia and cytoplasmic streaming Amoeba habitat: fresh/saltwater most free-living, some parasitic feeding: phagocytosis meal surrounded by pseudopods food taken into cell, into food vacuole reproduction: binary fission http: //www. youtube. com/watch? v=pv. Oz 4 V 699 gk
http: //www. biologyjunction. com/protozoan_notes_b 1. htm Question 14 What material makes up the foram shell?
Phylum Sarcodina Foraminiferans • • L. foramen, “little hole” + ferre, “to bear” habitat: warmer regions of the ocean test: porous shell made of Ca. CO 3 feeding: pseudopods projecting from pores in test form a sticky, interconnected net that entangles prey Forams in the White Cliffs of Dover in England
http: //www. biologyjunction. com/protozoan_notes_b 1. htm Question 15 What material makes up the radiolarian shell?
Phylum Sarcodina Heliozoans/Radiolarians • habitat: mostly freshwater • test: porous shell made of Si. O 2 – “sun animals”: due to appearance of pseudopods
Amoebiasis / Amoebic dysentery Pathogen: Entamoeba histolytica
Amoebiasis, Amoebic dysentery Transmission By putting anything into your mouth that has touched the stool of a person who is infected with E. histolytica. By swallowing something, such as water or food, that is contaminated with E. histolytica. By touching and bringing to your mouth cysts (eggs) picked up from surfaces that are contaminated with E. histolytica. Symptoms One in 10 people becomes sick from infection by E. histolytica Loose stools, stomach pain, stomach cramping Amebic dysentery: severe form of amebiasis associated with stomach pain, bloody stools, and fever. Rare: abscess in liver; infection of lungs or brain
Acanthamoeba infection Pathogen A. culbertsoni, A. polyphaga, A. castellanii, A. healyi, (A. astronyxis), A. hatchetti, A. rhysodes, and possibly others.
Acanthamoeba infection How does infection with Acanthamoeba occur? Acanthamoeba can enter the skin through a cut, wound, or through the nostrils. Amoebas can travel to the lungs and through the bloodstream to other parts of the body, especially the central nervous system (brain and spinal cord). Through improper storage, handling, and disinfection of contact lenses, Acanthamoeba can enter the eye and cause a serious infection.
http: //microbewiki. kenyon. edu/images/thumb/5/5 a/5963_lores. jpg/350 px-5963_lores. jpg Question 15 What structure do members of P. Sporozoa use to move around?
Phylum Sporozoa movement: non-motile habitat: inside hosts (worms, fish, birds, humans) feeding attach and feed by means of an apical complex http: //www. nature. com/scitable/content/ne 0000/ne 0000/14465688/f 6_baum_nrmicro 1465 -f 1. jpg
Phylum Sporozoa • reproduction: mostly complex life cycle – may involve >1 host – release sporozoites: tiny infectious cells http: //www. niaid. nih. gov/Site. Collection. Images/topics/malaria/lifecycle. Web. jpg
Malaria Pathogen Vector Plasmodium falciparum (can be fatal), female Anopheles P. vivax, P. ovale, and P. malariae
Malaria Transmission Infected Anopheles bites human, injects saliva containing Plasmodium sporozoites enter bloodstream, infect RBCs and liver cells where they multiply rapidly Infected cells burst and release toxins into bloodstream Symptoms Released toxins cause fever, chills, flu-like symptoms
Malaria Incidence
Malaria Incidence Tropical/subtropical regions • temp allows Anopheles to thrive • temp needed by parasites to complete growth w/in mosquito According the WHO: • 300 -500 M cases/year • ~1 -2 M deaths/year one of the leading causes of death Africa: 1 child/30 sec.
Malaria Eradication Eradicated from developed countries w/ temperate climate Major health problem in developing countries and in tropical/subtropical parts of the world Problems w/ eradication campaigns: 1. Resistance of mosquitoes to insecticides 2. Resistance of parasites to drugs 3. Administrative issues
Interesting websites: (and two of the sources for this lecture) Center for Disease Control’s Division of Parasitic Diseases Parasites and Health Webpage http: //www. dpd. cdc. gov/dpdx/HTML/Para_Health. htm Center for Disease Control’s Malaria Webpage http: //www. cdc. gov/malaria/